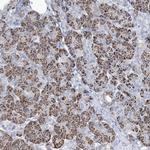
MOXD1 Antibody in Immunohistochemistry (IHC)

Search
Invitrogen
MOXD1 Polyclonal Antibody
{{$productOrderCtrl.translations['antibody.pdp.commerceCard.promotion.promotions']}}
{{$productOrderCtrl.translations['antibody.pdp.commerceCard.promotion.viewpromo']}}
{{$productOrderCtrl.translations['antibody.pdp.commerceCard.promotion.promocode']}}: {{promo.promoCode}} {{promo.promoTitle}} {{promo.promoDescription}}. {{$productOrderCtrl.translations['antibody.pdp.commerceCard.promotion.learnmore']}}
产品信息
PA5-57381
种属反应
宿主/亚型
分类
类型
抗原
偶联物
形式
浓度
规格
纯化类型
保存液
内含物
保存条件
运输条件
RRID
产品详细信息
Immunogen sequence: DINDKSITDS TVRVIWAYHH EDAGEAGPKY HDSNRGTKSL RLLNPEKTSV LSTALPYFDL VNQDVPIPNK DTTYWCQMFK IPVFQEKHHV IKVEPV
Highest antigen sequence identity to the following orthologs: Mouse - 84%, Rat - 90%.
靶标信息
The MOXD1 (Monooxygenase, DBH-like 1) gene encodes a protein that is part of the copper type II, ascorbate-dependent monooxygenase family, which includes enzymes such as dopamine beta-hydroxylase. Located on chromosome 6, the MOXD1 protein plays a role in the biosynthesis of bioactive amines, though its specific substrate and biological functions are less well characterized compared to its family members. This enzyme's activity is implicated in various physiological processes, including the metabolism of neurotransmitters and regulation of blood pressure. Research has suggested that MOXD1 might be involved in oncogenesis, with altered expression observed in certain cancer types. Further studies are needed to elucidate its precise physiological roles and potential as a therapeutic target.
仅用于科研。不用于诊断过程。未经明确授权不得转售。
篇参考文献 (0)
生物信息学
蛋白别名: DBH-like monooxygenase protein 1; dopamine-oxygenase; Monooxygenase X; MOX; similar to dopamine beta-hydroxylase; unnamed protein product
基因别名: dJ248E1.1; MOX; MOXD1; PRO5780; UNQ2493/PRO5780
UniProt ID: (Human) Q6UVY6
Entrez Gene ID: (Human) 26002